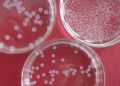
LUMiTainer verschiedener Größe

Mikrokapseln zur Verkapselung von Zellen, für die Elektronenmikroskopie und die Biotechnologie
- kugelförmige, elastische Mikrocontainer
- Standarddurchmesser 2 - 3 mm
- Kapselmembran auf Zellulosebasis
LUMiTainer™ sind kugelförmige, elastische Mikrocontainer mit einer auf Zellulose basierenden Membran. Die Kapselmembran ist etwa 100 µm dünn und erlaubt die Permeation von Molekülen bis zu einer Größe von ca. 10 kDa. Die Mikrokapseln haben einen Standarddurchmesser von 2 – 3 mm. Je nach Anforderungen können auch kundenspezifische Größen von 400 - 4000 µm und auch transparente, farbige oder fluoreszierende LUMiTainer™ hergestellt werden.
LUMiTainer™ vom Typ 01 (Standard) sind herstellungsbedingt mit unvernetzter Zellulosesulfatlösung gefüllt. Durch ein spezielles Herstellungsverfahren enthalten LUMiTainer™ des Typs 02 überwiegend eine isotonische NaCl-Lösung im Kapsellumen.
Als Werkzeug für die Elektronmikroskopie ermöglichen LUMiTainer™ die verlustfreie Präparation kleinster Mengen (<20 µl) von Zellen und Bioprodukten. Mikromengen und fragile Strukturen des Untersuchungsmaterials können einfach und zeitsparend präpariert werden und bleiben intakt, da mit diesem Verfahren die sonst üblichen Zentrifugationsschritte entfallen.
Für elektronenmikroskopische Untersuchungen werden die LUMiTainer™ mit dem gewünschten Material per Injektion gefüllt.
Die Objekte lassen sich dann in der Kapsel einfach fixieren, waschen, dehydratisieren, kritischpunkttrocknen, einbetten und sogar gefrieren. LUMiTainer™ erleichtern zu dem die Objektsuche im Schnittblock.
Das Injektions- und Präparationskit ist eine Spezialvorrichtung für das effektive Beschicken und Präparieren der LUMiTainer™ mit dem Untersuchungsmaterial. Es können bis zu vier LUMiTainer™ nacheinander befüllt werden.
Jede der 4 Aufnahme-Vorrichtungen für LUMiTainer™ kann anschließend als Mikroreaktionsgefäß (ca. 500 µl) genutzt werden. Darin können alle für die Präparation des Probengutes notwendigen Arbeitsschritte durchgeführt werden. Der Anschluss einer Absaugvorrichtung ermöglicht dabei den material- und zeitsparenden Medienwechsel wie z.B. bei Dehydratisierungs- und Waschvorgängen.
Sie haben Fragen zu SediVal™ oder möchten bestellen? Bitte kontaktieren Sie uns.
| Art.-Nr. |
Art.-Bez. |
Beschreibung |
Menge / VE |
| 201-00050 | LUMiTainer™ Typ 01 | Kapseln im Röhrchen | 50 Kapseln |
| 201-00100 | LUMiTainer™ Typ 02 | Kapseln im Röhrchen | 100 Kapseln |
| 301-00000 | Injektionsset | 1 |